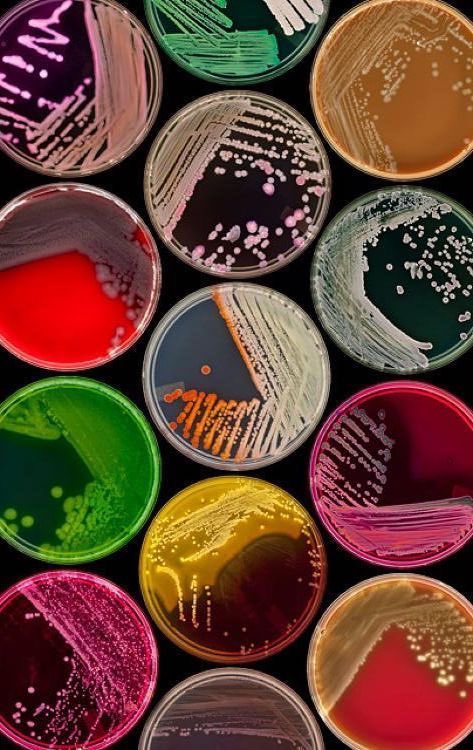
Manar_Alju's tweet image. أحب أتفرج على أطباق بتري والله فن 🧫

Fatmiah⭒
@FalliM7
Strong Interest in Scientific Research and Reading books|#Biotechnology student |@TaifUniversity|🌱|📚🔬|👩🔬|
عندي مهام كثيره لكن وقعت بُحب كتاب وبكل مرة أقول اخر صفحة اقرأها الآن باقي لي ٣٠ صفحة من أصل ٤٠٤!!
﴿وَأَن لَيسَ لِلإِنسانِ إِلّا ما سَعى وَأَنَّ سَعيَهُ سَوفَ يُرى﴾
أكبر مصنع لقاحات في الشرق الأوسط. الأول من نوعه في السعودية.
اليوم قُمت بتنظيم وحضور دورة أدوات مُبتكرة لدعم الإسعافات الأولية، كانت رائعة جدًا واستفدت منها من أفضل الدورات التي اقامها نادينا نادي الجينوم🩵


مساء الخير ، هدفي الفترة الحالية تقويه مهاراتي بالمعمل سويت لستة لمراكز الابحاث اللي تقدم دورات تدريبية وبدأت فيها. تحت هذا الثريد راح اشارككم الدورات اللي بأخذها مع تفاصيلها للفائدة 👩🏻🔬
العلم لا يُمكن أن يُنال بالكذب، قد تشتري أو تزور ورقة الشهادة ولكن لن تحصل على العلم.
بتوفيق الله تعالى ، أسسنا المنظومة المتكاملة لتوطين الصناعات الطبية الحيوية : Biotechnology manufacturing •صناعة الإنسولين •صناعة اللقاحات البشرية •صناعة اللقاحات الحيوانيّة •البحث والتطوير والإبتكار في مجال اللقاحات والأدوية الحيوية •التعليم والتدريب في مجال…




في إنجاز سعودي على مستوى العالم .. العالم السعودي "عمر بن يونس ياغي" ينال جائزة نوبل للكيمياء. -

و قد تتفوق هذه التقنية على تقنية كريسبر , Bridge RNA و تمكن العلماء من تعديل طفرات مسببة لبعض الامراض مما يتيح الاستفادة منها في العلاج الجيني 🧬


العلماء اكتشفوا اداة جديدة للتحرير الجيني و تستخدم الجينات القافزة في البكتيريا 👏🧬 " "we report the discovery of bridge RNAs and 3 atomic structures of the first natural RNA-guided recombinase - a new mechanism for programmable genome design "
المُهتم بالمناقشات يحجز الآن لاتفوتوا هالفرصة بالذات الخريجين❤️
خبر حصري لأهالي الطائف ♥️ وأخيراً بدأ التسجيل 🤩 المقاعد جداً محدودة 🙏🏻 انضم إلينا في أمسية "دردشة وسوالف مهنية" من مبادرة #BioNoLimits، حيث نجمع الخبراء بالشباب لكسر الحواجز وتبادل الخبرات. لتجد الإجابات على أسئلتك، وتلتقي بقصص نجاح ملهمة، وتبني شبكة علاقاتك المهنية.
خبر حصري لأهالي الطائف ♥️ وأخيراً بدأ التسجيل 🤩 المقاعد جداً محدودة 🙏🏻 انضم إلينا في أمسية "دردشة وسوالف مهنية" من مبادرة #BioNoLimits، حيث نجمع الخبراء بالشباب لكسر الحواجز وتبادل الخبرات. لتجد الإجابات على أسئلتك، وتلتقي بقصص نجاح ملهمة، وتبني شبكة علاقاتك المهنية.
This is what it looks like when plants talk to each other. Scientists from Japan made it visible: #STEM #PlantBiology #Biotechnology
خلال الأسابيع الماضية شاركتُ ،في برنامج التدريب الصيفي العلمي المكثف مع عيادة رعاية البيطري بالتعاون مع FSMLJ. كانت تجربة رائعة،أتاحت لي العديد من فُرص بالتعلم وخوض في التجارب العملية ،والتعامل مع الحيوانات بشكل لطيف. والحمد لله، كانت النهاية سَعيدة🩵🩵




أهل الطائف 📢 من الطائف ؟ او صيفك بتقضيه بالطائف؟ ومهتم بعلوم وصحة الحيوان ؟ يسر مجموعة @FSMLJ_ أن تقدم لكم " برنامج صيفي علمي مكثف " بالشراكة مع @rieayavt تبدأ رحلتك العلمية :- ⏰ لمدة ٤ أسابيع - بمعدل 58 ساعة تدريب 🔗 للتسجيل ⬇️ chat.whatsapp.com/FX74T1NW7Yd16P… للتفاصيل كمل ⬇️

United States Trends
- 1. #GMMTV2026 2.6M posts
- 2. Good Tuesday 29.4K posts
- 3. MILKLOVE BORN TO SHINE 418K posts
- 4. #tuesdayvibe 2,178 posts
- 5. WILLIAMEST MAGIC VIBES 57.6K posts
- 6. Mark Kelly 216K posts
- 7. MAGIC VIBES WITH JIMMYSEA 68.7K posts
- 8. JOSSGAWIN MAGIC VIBES 22.6K posts
- 9. Chelsea 219K posts
- 10. #JoongDunk 101K posts
- 11. Alan Dershowitz 3,273 posts
- 12. TOP CALL 9,434 posts
- 13. AI Alert 8,249 posts
- 14. #ONEPIECE1167 8,559 posts
- 15. Barca 84.4K posts
- 16. Maddow 15.4K posts
- 17. Check Analyze 2,487 posts
- 18. Jim Croce N/A
- 19. Token Signal 8,664 posts
- 20. Unforgiven 1,191 posts
Something went wrong.
Something went wrong.